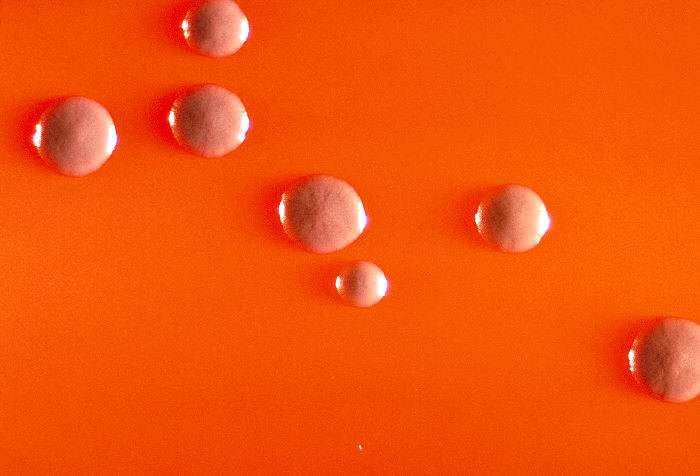
Colonias de Corynebacterium diphtheriae subsp. gravis.

Corynebacterium diphtheriae pertenece al género Corynebacterium, familia Corynebacteriaceae. Se trata de bacilos Gram positivo, pequeños, pleomórficos, inmóviles, aerobios facultativos, no encapsulados, que se encuentran aislados, en parejas o agrupados formando una especie de V, de letras chinas o de empalizada.
En el caso de la especie C. diphtheriae se han descrito cuatro biotipos: gravis, mitis, intermedius y belfanti. El biotipo gravis es el más frecuente.
La apariencia de las colonias varía en función del medio de cultivo utilizado.
Viabilidad, propagación y transmisión
Reservorio
Mucosas, principalmente de las vías respiratorias superiores y piel del hombre.
Hospedadores
Humano. Raramente vacas, gatos y caballos.
Dosis Infectiva Mínima (DIM)
Se desconoce en la actualidad.
Supervivencia ambiental
Puede sobrevivir en el exterior de 7 días a 6 meses en superficies secas (13).
Formas de resistencia
No presenta formas de resistencia.
Mecanismo de propagación y transmisión
C. diphtheriae se transmite de persona a persona, principalmente por la inhalación o el contacto de las mucosas con gotitas aerosolizadas (gotitas de Flügge), procedentes de la saliva o de las secreciones respiratorias de personas infectadas o de portadoras asintomáticas (personas infectadas con C. diphtheriae en la nariz o la garganta sin síntomas).
Otras formas de transmisión menos frecuentes son la contaminación de heridas, quemaduras o picaduras de insectos; el contacto con los exudados o las secreciones de las heridas abiertas de personas enfermas y, más raramente, el contacto con ropas (ropa de cama), superficies (juguetes, etc.) o alimentos contaminados con secreciones de personas enfermas, y la ingesta accidental, al comer o fumar con las manos contaminadas (8) (13).
El paciente con difteria respiratoria puede transmitir la enfermedad desde los 7 días antes del inicio de los síntomas hasta 2-3 semanas después, si no tiene el tratamiento adecuado, o durante 6 meses o más si se trata de un portador crónico; pero si el paciente es tratado adecuadamente con antibiótico, suele dejar de ser contagioso a las 48 horas (5) (13).
En los países donde no se dan casos de difteria es extremadamente raro el aislamiento del microorganismo en personas sanas.
Vías de entrada
Respiratoria. Mucosas. Dérmica. Parenteral. Digestiva.
Distribución geográfica
Mundial.
Aunque en la mayoría de los países de Europa no hay difteria, siguen apareciendo casos en Letonia, Federación Rusa y Ucrania. En otras zonas del mundo la difteria sigue siendo endémica, como en zonas de Latinoamérica (Brasil, Ecuador) y región del Caribe, Sudeste Asiático (Tailandia, India, Indonesia, Nepal, Filipinas), Oriente Medio y África (Argelia, Madagascar, Zambia, Nigeria), principalmente en zonas donde no hay una adecuada inmunización infantil (5) (9) (13).
En España los casos suelen ser importados (5).
Efectos sobre la salud
Grupo de riesgo
2 T, V
(Ver Anexo II RD 664/1997 )Infección
Difteria: el periodo de incubación es normalmente de 2-7 días o más. La infección puede afectar a cualquier mucosa o zona de la piel. Las principales manifestaciones clínicas son la difteria respiratoria y la difteria cutánea.
La difteria respiratoria afecta principalmente a la mucosa nasal, amígdalas, laringe y faringe. El síntoma más característico es la formación de una membrana que se localiza normalmente en la faringe, se engrosa, va adquiriendo una coloración blanco-grisácea y se puede extender hacia la pared posterior de la faringe o de la tráquea. La membrana se hace adherente y, cuando se intenta despegar, sangra con facilidad. Pero, a veces, particularmente en personas vacunadas, la membrana faríngea no aparece. Otros síntomas característicos son dolor de garganta, fiebre baja, amigdalitis o faringitis, mal estar general y dolor e inflamación de los ganglios cervicales.
La difteria cutánea afecta a la piel y mucosas principalmente de zonas expuestas. Se suele producir por la infección de heridas preexistentes como picaduras de insectos o heridas quirúrgicas. Se manifiesta como una lesión inflamatoria acompañada de vesículas, que evoluciona hacia una úlcera crónica no progresiva bien delimitada, además puede aparecer una membrana gris sucia y coinfección de otras bacterias.
La difteria cutánea raramente se asocia a signos de toxicidad y puede ser indistinguible de otros trastornos dermatológicos crónicos como eczemas o psoriasis.
La gravedad de la difteria depende de la extensión de las lesiones y de la difusión de la toxina, pudiendo aparecer complicaciones como bloqueo de las vías respiratorias, daño del músculo cardíaco (miocarditis), daño neurológico (polineuropatía) e infección pulmonar (insuficiencia respiratoria o neumonía) (4) (5).
La letalidad de la difteria se estima entre el 5 % y el 10 % o el 25 % si el tratamiento no es adecuado (5).
Efectos alérgicos (Ver Anexo II RD 664/1997 ) / (Ver Allergen )
No se han descrito
Efectos tóxicos (Ver Anexo II RD 664/1997 )
El principal factor de virulencia del género Corynebacterium es su capacidad de producir una exotoxina necrotizante. Todos los biotipos de C. diphtheriae, excepto el belfanti, pueden producir exotoxina (4).
La exotoxina diftérica es la causante de las manifestaciones locales y de los efectos tóxicos sistémicos, pues destruye los tejidos. El tejido dañado o necrótico a los 2 o 3 días forma un recubrimiento gris grueso o “pseudomembrana”.
La toxina es letal a una dosis inferior a 0,1 µg/kg (microgramos de toxina por kilo de peso corporal en humanos) (13).
Efectos cancerígenos (Ver International Agency for Research On Cancer - IARC )
No se han descrito
Efectos en la maternidad
No se han descrito
Enfermedad
| CIE-10 | Nombre | Enfermedad de Declaración Obligatoria |
|---|---|---|
| A36 | Difteria | Sí |
Actividades laborales con riesgo
Clasificación Nacional de Actividades Económicas (CNAE)
| CNAE 2009 | Descripción |
|---|---|
| P8424 | Orden público y seguridad |
| P8425 | Servicios de extinción de incendios |
| Q8510 | Educación preprimaria |
| Q8520 | Educación primaria |
| R8610 | Actividades hospitalarias |
| R8621 | Actividades de medicina general y de medicina familiar y comunitaria |
| R8622 | Actividades de otras especialidades médicas |
| R8623 | Actividades odontológicas |
| R8699 | Otras actividades sanitarias n.c.o.p. |
| R8710 | Asistencia en establecimientos residenciales con cuidados sanitarios |
| R8720 | Asistencia en establecimientos residenciales para personas que padecen una enfermedad mental o una drogodependencia o que han recibido un diagnóstico al respecto |
| R8731 | Asistencia en establecimientos residenciales para personas mayores |
| R8732 | Asistencia en establecimientos residenciales para personas con discapacidad física |
| R8811 | Actividades de servicios sociales sin alojamiento para personas mayores |
| R8812 | Actividades de servicios sociales sin alojamiento para personas con discapacidad |
| R8891 | Actividades de cuidado diurno de niños |
| T9621 | Peluquerías y barberías |
Clasificación Nacional de Ocupaciones (CNO)
| CNO 2011 | Descripción |
|---|---|
| 2111 | Médicos de familia |
| 2112 | Otros médicos especialistas |
| 2121 | Enfermeros no especializados |
| 2122 | Enfermeros especializados (excepto matronos) |
| 2240 | Profesores de enseñanza primaria |
| 2251 | Maestros de educación infantil |
| 2252 | Técnicos en educación infantil |
| 2311 | Profesores de educación especial |
| 3311 | Técnicos en radioterapia |
| 3312 | Técnicos en imagen para el diagnóstico |
| 5611 | Auxiliares de enfermería hospitalaria |
| 5612 | Auxiliares de enfermería de atención primaria |
| 5622 | Técnicos de emergencias sanitarias |
| 5629 | Trabajadores de los cuidados a las personas en servicios de salud no clasificados bajo otros epígrafes |
| 5710 | Trabajadores de los cuidados personales a domicilio |
| 5721 | Cuidadores de niños en guarderías y centros educativos |
| 5722 | Cuidadores de niños en domicilios |
| 5811 | Peluqueros |
| 5910 | Guardias civiles |
| 5921 | Policías nacionales |
| 5922 | Policías autonómicos |
| 5923 | Policías locales |
Prevención y control
Desinfectantes
C. diphtheriae es sensible a clorohexidina a una concentración mínima inhibitoria de 5 miligramos por litro.
No se dispone de información específica, pero la mayoría de las bacterias vegetativas se inactivan con hipoclorito sódico al 1 %, etanol al 70 %, glutaraldehído, yodo, peróxido de hidrogeno, ácido peracético y compuestos de amonio cuaternario.
Inactivación física
No se dispone de información específica, pero la mayoría de las bacterias vegetativas se inactivan con calor húmedo a 121 °C durante al menos 15-30 minutos y con calor seco a 160 ºC -170 °C durante al menos 1-2 horas.
Antimicrobianos
Antitoxina diftérica y antibióticos: penicilina (amoxicilina), macrólidos (azitromicina, eritromicina), cefalosporinas y tetraciclina.
Vacunación
Vacuna combinada Tétanos-difteria (Td): es una vacuna de aplicación sistemática recomendada por el Sistema Nacional de Salud, por lo que todos los trabajadores, independientemente de su profesión, deberían estar al día con el calendario de vacunación para adultos establecido por el Sistema Nacional de salud (12).
Además, se recomienda especialmente la administración de la vacuna Td a los trabajadores que no posean una correcta inmunización y realicen actividades en centros sanitarios, actividades de orden público, seguridad y servicios sociales (bomberos, policía, personal militar y de emergencias, prisiones, centros de discapacitados, geriátricos, etc.) y a los que viajen a zonas endémicas (5) (11).
Medidas preventivas generales
Vacunación del trabajador y del personal potencialmente expuesto.
Debido a que la enfermedad es muy contagiosa, es recomendable que los trabajadores con una infección activa sean separados del trabajo hasta la finalización del periodo contagioso y, si son portadores asintomáticos, es recomendable que eviten el contacto con personas no inmunizadas.
Para impedir la propagación de la enfermedad, la persona infectada debe taparse siempre que tosa con pañuelos desechables y lavarse frecuentemente las manos, especialmente después de toser o estornudar. En caso de infección de la piel, debe aislar la herida con apósitos impermeables estériles (9).
Control higiénico- sanitario de los animales.
Diseño adecuado de los locales de trabajo, con superficies impermeables, lisas y fáciles de limpiar. Adecuado mantenimiento, limpieza, desinfección y esterilización de herramientas, equipos y superficies.
Eliminación o reducción al mínimo del material cortante o punzante o utilizarlo con las debidas protecciones y precauciones.
Buenas prácticas de higiene: lavado de manos con agua y jabón al comenzar y finalizar la jornada laboral, después de quitarse los guantes y tras el contacto con elementos contaminados; evitar el contacto de las manos con los ojos, la nariz o la boca; evitar la exposición de heridas abiertas, cubriéndolas con apósitos estériles e impermeables. Utilización de ropa de trabajo y equipos de protección individual adecuados.
Precauciones en centros sanitarios
En el ámbito sanitario y hospitalario se deberán adoptar las Precauciones Estándar y, además, las Precauciones por Gota o por Contacto en función de la manifestación clínica de la infección como indica la siguiente tabla (2) (5) (14):
| Infección | Tipo de Precaución | Duración |
|---|---|---|
| Difteria respiratoria | Gota |
Hasta que dos cultivos de las muestras de garganta y nariz, tomados al menos con 24 horas de diferencia y al menos 24 horas después de completar el tratamiento antibiótico, sean negativos. Si no se pueden obtener cultivos, el aislamiento se mantendrá hasta 14 días después de iniciado el tratamiento adecuado con antibiótico. |
| Difteria cutánea | Contacto |
Hasta que dos cultivos de las muestras de las lesiones cutáneas, tomados al menos con 24 horas de diferencia y al menos 24 horas después de completar el tratamiento antibiótico, sean negativos. Si no se pueden obtener cultivos, el aislamiento se mantendrá hasta 14 días después de iniciado el tratamiento adecuado con antibiótico. |
EPI
Protección respiratoria: mascarillas autofiltrantes tipo FFP2, preferiblemente FFP3 para operaciones en las que se generen bioaerosoles.
Protección de las manos: guantes de protección frente a microorganismos, cuando sea inevitable el contacto con pacientes o materiales infecciosos. Los guantes deberían solaparse completamente con las mangas de la ropa de protección o de la ropa de trabajo.
Protección ocular o facial: gafa de protección de montura universal en caso de riesgo de contacto accidental mano/guante contaminado-ojo, o pantalla de protección facial (símbolo de marcado en montura: 3) en caso de riesgo de exposición a salpicaduras, o gafa de protección de montura integral con hermeticidad frente a partículas (símbolo de marcado en montura: 4), en caso de riesgo de exposición a polvo.
Ropa de protección frente agentes biológicos de cuerpo completo o parcial (bata desechable impermeable que cubra la mayor parte del cuerpo y puños ajustados).
Seguridad en laboratorio
Nivel de contención: 2
Los principales riesgos son la exposición a bioaerosoles o gotitas infecciosas, el contacto dérmico o mucoso y la inoculación e ingestión accidental.
Las muestras o especímenes más peligrosos son las secreciones respiratorias y de las heridas, la sangre y la piel.
Se requieren las prácticas y la contención de un nivel 2 de bioseguridad para realizar cultivos de la bacteria y para manipular muestras o animales infectados. Se debe trabajar dentro de una cabina de seguridad biológica cuando se puedan producir bioaerosoles, salpicaduras o se trabaje con grandes cantidades; se debe evitar o reducir el uso de material cortante o punzante; se deben seguir unas correctas prácticas de higiene: lavado de manos, uso de guantes y ropa de trabajo; y se deben segregar y eliminar de forma adecuada los residuos.
Bibliografía
- Acha, P. N., & Szyfres, B. (2003). Zoonosis y enfermedades transmisibles comunes al hombre y a los animales (3ª ed.): Volumen I. Bacteriosis y micosis. Organización Panamericana de la Salud.
- Centers for Disease Control and Prevention (CDC). 2007 Guideline for isolation precautions: preventing transmission of infectious agents in healthcare settings. Actualizado en 2023.
- Centers for Disease Control and Prevention (CDC). (2020). Biosafety in microbiological and biomedical laboratories (6th ed.).
- Centers for Disease Control and Prevention (CDC). (2021). Diphtheria.
- Centro Nacional de Epidemiología. Instituto de Salud Carlos III (ISCIII). Red Nacional de Vigilancia Epidemiológica. (2015). Protocolo de vigilancia de difteria. En Protocolos de la Red Nacional de Vigilancia Epidemiológica.
- Comisión de Salud Pública del Consejo Interterritorial del Sistema Nacional de Salud. Ministerio de Sanidad y Consumo. (2001). Protocolo de vigilancia sanitaria específica para los/as trabajadores/as expuestos a agentes biológicos.
- Commission specialisee maladies transmisibles. Haut Conseil de la Santé Publique. Ministère du Travail, de l’Emploi et de la Santé. (2011). Conduite à tenir lors de l’apparition d’un cas de diphtérie.
- IFA Institute for Occupational Safety and Health of German Social Accident Insurance. (2016). Corynebacterium diphtheriae. Gestis Biological Agents Database.
- Institut National de Recherche et de Sécurité (INRS). (2022). Diphtérie. Base de donées EFICATT.
- Institut National de Recherche et de Sécurité (INRS). (2023). Corynebacterium diphtheriae. BAse d'OBservation des Agents Biologiques (BAOBAB).
- Ponencia de Programa y Registro de Vacunaciones. Consejo Interterritorial. Sistema Nacional de Salud. (2018). Vacunación en grupos de riesgo de todas las edades y en determinadas situaciones. Ministerio de Sanidad, Consumo y Bienestar Social.
- Ponencia de Programa y Registro de Vacunaciones. Consejo Interterritorial. Sistema Nacional de Salud. (2018). Vacunación en población adulta. Ministerio de Sanidad, Consumo y Bienestar Social.
- Public Health Agency of Canada. (2011). Corynebacterium diphtheriae. Pathogen Safety Data Sheets.
- Servicio Riojano de Salud. (2008). Precauciones de aislamiento en centros sanitarios.
- World Health Organization (WHO). (2023). Diphtheria.